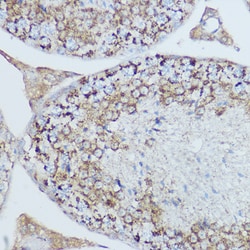
Invitrogen MTCO2 Polyclonal Antibody 100 &mu;L; Unconjugated:Anticuerpos

missing translation for 'onlineSavingsMsg'
Learn More
Learn More
Invitrogen™ MTCO2 Polyclonal Antibody


Descripción
Positive Samples: Mouse liver, Mouse heart, Mouse kidney, Rat liver, Rat kidney; Cellular Location: Mitochondrion inner membrane, Multi-pass membrane protein Immunogen sequence: GHQWYWSYEY TDYEDLCFDS YMIPTNDLKP GELRLLEVDN RVVLPMELPI RMLISSEDVL HSWAVPSLGL KTDAIPGRLN QATVTSNRPG LFYGQCSEIC.
Component of the cytochrome c oxidase, the last enzyme in the mitochondrial electron transport chain which drives oxidative phosphorylation. The respiratory chain contains 3 multisubunit complexes succinate dehydrogenase (complex II, CII), ubiquinol-cytochrome c oxidoreductase (cytochrome b-c1 complex, complex III, CIII) and cytochrome c oxidase (complex IV, CIV), that cooperate to transfer electrons derived from NADH and succinate to molecular oxygen, creating an electrochemical gradient over the inner membrane that drives transmembrane transport and the ATP synthase. Cytochrome c oxidase is the component of the respiratory chain that catalyzes the reduction of oxygen to water. Electrons originating from reduced cytochrome c in the intermembrane space (IMS) are transferred via the dinuclear copper A center (CU(A)) of subunit 2 and heme A of subunit 1 to the active site in subunit 1, a binuclear center (BNC) formed by heme A3 and copper B (CU(B)). The BNC reduces molecular oxygen to 2 water molecules using 4 electrons from cytochrome c in the IMS and 4 protons from the mitochondrial matrix. [UniProt].

Especificaciones
Especificaciones
| Antígeno | MTCO2 |
| Aplicaciones | ELISA, Immunohistochemistry (Paraffin), Western Blot, Immunocytochemistry |
| Clasificación | Polyclonal |
| Concentración | 1.01 mg/mL |
| Conjugado | Unconjugated |
| Formulación | PBS with 50% glycerol and 0.02% sodium azide; pH 7.3 |
| génica | MT-CO2 |
| N.º de referencia del gen | P00403, P00405, P00406, P35354 |
| Alias de gen | ACI60_gp02; Co2; COII; COX2; COXII; cyclooxygenase; cytchrome c oxidase sububnit 2; Cytochrome c oxidase polypeptide II; Cytochrome c oxidase subunit 2; cytochrome c oxidase subunit II; mitochondrially encoded cytochrome c oxidase II; Mtco2; MT-CO2; OXI1; OXII; Q0250 |
| Símbolos de los genes | COX2, MT-CO2 |
| Show More |
Product Title
By clicking Submit, you acknowledge that you may be contacted by Fisher Scientific in regards to the feedback you have provided in this form. We will not share your information for any other purposes. All contact information provided shall also be maintained in accordance with our Privacy Policy.
Spot an opportunity for improvement?